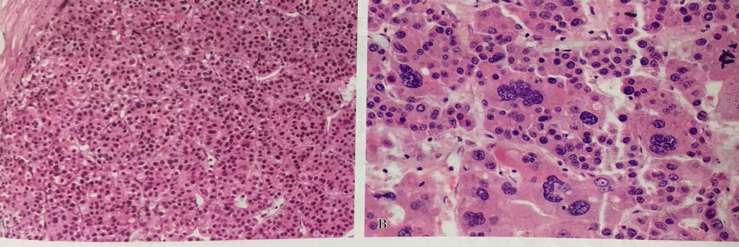

-
1 理论知识
-
2 微课视频
-
3 PPT
-
4 思维导图
-
5 临床病例讨论
-
6 知识拓展
第十二节 消化系统常见肿瘤

一、食管肿瘤
(一)良性肿瘤
少见。上皮源性的有鳞状上皮乳头状瘤(squamous papilloma),常认为与人乳头状瘤病毒(HPV)感染有关。非上皮源性肿瘤多见的有平滑肌瘤。还可见脂肪瘤、血管瘤等,均少见。
(二)恶性肿瘤
有食管癌、食管肉瘤、恶性黑色素瘤等。以食管癌最多见。
食管癌(carcinoma of esophagus)
1. 发病年龄以40岁以上男性发病较多,60~64岁年龄组最高。早期常缺乏明显症状,中、晚期以进行性吞咽困难为主要临床表现。
2. 病因和发病机制
环境因素、某些致癌物和病毒感染是重要的相关因素。我国高发区地质土壤中缺钼,饮水和粮食中硝酸盐、亚硝酸盐和二级胺含量明显增多,导致致癌物亚硝胺合成增多,被认为是引起食管癌的重要因素。食物中缺维生素B2、维生素A及锌可能是诱发因素。饮食过热、饮酒及吸烟所引起食管上皮的损伤与食管癌发生相关。近年来,人乳头状瘤病毒(HPV)与食管癌的关系引起关注,病毒基因整合入宿主细胞基因组,有可能活化癌基因引起肿瘤发生。
3. 病理变化
食管癌好发于食管中段,下段次之、上段较少。可分为早期癌和中晚期癌。

(1)早期癌 病变较局限,仅累及粘膜层或粘膜下层,未侵及肌层,无淋巴结转移。临床症状不明显,易被忽视。肉眼观可分为四型:①隐伏型;②糜烂型;③斑块型;④乳头型。
(2)中、晚期癌 临床症状明显,就诊和发现机会较多。肉眼观可分四型:①髓质型:较多见,累及食管周径全部或大部,管壁内浸润生长;②蕈伞型:圆形或卵圆形向腔内突起;③溃疡型:多见,大小不等,外形不整,周边隆起,底部不平,出血、坏死及转移多见,梗阻较晚;④缩窄型:多累及食管全周,管壁内浸润生长,因纤维组织增形成环形狭窄,近端食管扩张,出现梗阻较早,出血和转移较晚。

镜下,组织学类型分为:
①鳞状细胞癌:最常见,达90%,依分化程度分高、中、低三级;

②腺癌:不多见,与Barrett食管相关,亦依分化程度不同分三级;③未分化癌,较少见,恶性程度高。

4. 扩散和转移
(1)直接浸润 食管上段癌可侵及喉、气管和颈部软组织;中段癌可侵及支气管、肺;下段癌可侵及贲门、膈肌和心包等处。
(2)淋巴道转移 常见,并循淋巴引流途径。上段癌可转移至食管旁、喉、颈部及纵隔淋巴结;中段癌可转移至食管旁及肺门淋巴结;下段癌可转移至食管旁、贲门、胃左动脉旁和腹腔上部淋巴结。形成局部淋巴结转移后,可继续沿淋巴管向远处淋巴结转移。
(3)血道转移 晚期患者可转移至肝、肺、亦可转移至肾、骨和肾上腺等处。
4. 临床病理联系
早期食管癌症状不明显,可表现为咽下梗噎感,胸骨后和剑突下疼痛、食物滞留感和异物感、咽喉部干燥和紧缩感,与病变类型有关。中、晚期患者表现为进行性吞咽困难及食物返流,如累及相邻组织、器官可出现相应表现如压迫喉返神经出现声音嘶哑,侵及气管或支气管出现呛咳、呼吸困难等。
二、胃癌
胃癌(gastric carcinoma)胃癌好发于40~60岁,男多于女,年轻者发病率有增加趋势。
(一)病因及发病机制
门螺杆菌(HP)与胃癌的关系备受关注。HP感染致粘膜损伤,腺体萎缩,胃酸分泌减少,其它细菌得以生长繁殖可使硝酸盐还原为亚硝酸盐,进而合成具有致癌效应的N-亚硝基化合物增多。HP可活化乙醇脱氢酶致乙醛生成增加,乙醛可造成粘膜上皮和DNA损伤。损伤后细胞再生修复活跃,细胞转换率增加,DNA修复障碍,突变的基因逃逸免疫监控而导致细胞转化。抗HP抗体阳性的胃病患者中胃癌的发病率显著增加。
胃癌发病可能与土壤地质因素、饮食习惯和食物构成成份的差异有密切关系。高盐饮食、好食熏制鱼肉食品、霉菌感染食物及环境和体内N-亚硝基化合物前体成分如亚硝酸盐等增多均与胃癌发生呈不同程度的相关。

胃癌发生过程中的基因变化已多有阐述。癌基因如c-myc、erbB-2的过度表达,抑癌基因如P53、K-ras和APC(adenomatous polyposis coli)的突变和缺失已得到证实。
某些癌前病变如慢性萎缩性胃炎、胃息肉、慢性胃溃疡、恶性贫血、残胃等在持续长久的损伤和再生过程中,导致胃腺颈部和胃小凹底部的干细胞反复增生,经化生、异型增生而癌变。
(二)病理变化和类型
胃癌好发于胃窦部、胃小弯及前后壁,其次贲门部。依据癌组织侵及深度,将其分为早期胃癌和进展期胃癌。
1.早期胃癌(early gastric carcinoma) 不论范围大小,是否有周围淋巴结转移,癌组织只限于粘膜层或粘膜下层者均称为早期胃癌。局限于粘膜固有膜者称粘膜内癌,浸润至粘膜下层者称粘膜下癌。病变直径<0.5cm者称微小癌。0.6~1.0cm者称小胃癌。早期胃癌术后五年生存率>90%,微小癌和小胃癌术后5年生存率达100%。
早期胃癌肉眼观可分三种类型:
(1)隆起型(protruded type,I型):病变隆起如息肉状,高出粘膜相当于粘膜厚度2倍以上,有蒂或无蒂。
(2)表浅型(superficial type,II型):病变无明显隆起和凹陷,局部粘膜变化轻微。此型可再细分为:①表浅隆起型(IIa型);稍隆起,但高度<粘膜厚度的2倍;②表浅平坦型(IIb型);③表浅凹陷型(IIc型),较周围粘膜稍凹陷伴糜烂。
(3)凹陷型(excavated type,III型):病变有明显凹陷或溃疡,但限于粘膜下层,此型多见。
上述各型中,年轻者多凹陷型,年长者多隆起型。组织学分型,管状腺癌最多见,次为乳头状腺癌及印戒细胞癌,未分化癌少见。

2.进展期胃癌(advanced gastric carcinoma)
癌组织侵达肌层或更深者,不论其有否淋巴结转移,均称为进展期胃癌。也称为中、晚期癌。侵犯越深,预后越差,转移可能性越大。
肉眼观通常分为三种类型:
(1)息肉型或蕈伞型(polypoid or fungating type)
多为早期隆起型发展而致,病变向腔内生长,呈结节状、息肉状或菜花状,表面常有溃疡形成。
(2)溃疡型(ulcerative type)
多为早期凹陷型发展而致。病变处组织坏死脱落形成溃疡。底部常浸润性生长,边缘隆起呈火山口状,质脆,易出血。需与慢性消化性溃疡鉴别。
消化性溃疡与溃疡型胃癌的肉眼区别
特 征 | 消化性溃疡(良性) | 溃疡型胃癌(恶性) |
外观 | 圆或椭圆形 | 不规则、火山口状 |

(3)浸润型(infiltrating type)癌组织在胃壁内局部弥漫性浸润生长,与周围组织无明显界限,弥漫浸润时胃壁增厚、变硬、皱襞大多消失、弹性减退、胃腔缩小,形状如同皮革制成的囊袋,称为革囊胃(linitis plastica)。

进展期胃癌的组织学类型分为乳头状腺癌或管状腺癌,伴不同程度(高、中、低)分化、粘液腺癌、印戒细胞癌和未分化癌等。
依据胃癌组织发生不同将其分为肠型和胃型。肠型胃癌由肠化上皮发生,多伴肠上皮化生,尤结肠上皮化生,分泌粘液量少,主要为唾液酸粘液和硫酸粘液,多为高分化腺癌;胃型胃癌由非肠化上皮发生,少伴肠上皮化生,分泌粘液量多,多为中性粘液,多为印戒细胞癌或粘液腺癌。
(三)扩散途径
1.直接扩散 癌组织浸润到浆膜层后可直接扩散至邻近器官和组织,与癌所在部位相关。胃窦癌可侵犯十二指肠大网膜、肝左叶和胰腺等;贲门胃底癌可侵犯食管、肝和大网膜等。
2.淋巴道转移 依淋巴回流顺序,由近及远,由浅及深发生淋巴结转移。以胃小弯侧胃冠状静脉旁和幽门下淋巴结最多见,进一步可转移至腹主动脉旁、肝门处淋巴结而达肝脏。转移到胃大弯处淋巴结可进一步累及大网膜淋巴结。晚期经胸导管转移至左锁骨上淋巴结。早期胃癌可经淋巴道转移,但少见。
3.血道转移 多晚期,常经门静脉转移到肝,其次为肺、骨及脑。
4.种植性转移 胃癌,尤胃粘液腺癌或印戒细胞癌侵透浆膜后脱落,似播种样种植于大网膜、直肠膀胱陷凹及盆腔器官的腹膜等处。最常种植部位为卵巢,多双侧,称Krukenberg瘤,即转移性卵巢粘液癌, 也可经淋巴道或血道转移而致。
(四)临床病理联系
早期胃癌多无明显临床症状。进展期胃癌可出现食欲不振、消瘦、无力、贫血等。上腹部疼痛逐渐加重,且与进食无明确关系或进食后加重。侵及血管可出血、呕血或便血,甚至大出血。贲门癌可导致吞咽困难。幽门癌可引起幽门梗阻。侵透浆膜可穿孔导致弥漫性腹膜炎。扩散或转移可引起如腹水、黄疸等相应症状。
三、大肠癌
大肠癌(carcinoma of the large intestine) 又可称结、直肠癌(colorectal cancer)。发病年龄多在40~60岁,且趋向年轻化。男性稍多于女性。
(一)病因及发病机制
环境因素和遗传因素与大肠癌的发生密切相关。
环境因素中,高脂肪、高蛋白和低纤维饮食与大肠癌的发生密切相关,其可引致肠道菌丛比例失调、肠道排空时间改变和胆酸、氨基酸、中性胆固醇等物质数量和性质的变化。厌氧菌如梭状芽胞杆菌通过酶的作用使胆酸、氨基酸转化为致癌物和促癌物,而低纤维饮食致肠排空延缓,使细菌与胆酸、氨基酸等作用时间延长,致癌物与粘膜上皮接触时间长而易使细胞发生转化。分子机制的研究表明,在大肠癌发生过程中的不同阶段出现癌基因如K-ras、C-myc等的突变或过表达,抑癌基因如APC、DCC(deleted in colorectal cancer)、MCC(mutated in colorectal cancer)、P53、P16等的缺失或突变,从而导致癌的发生。遗传因素中,已检测到家族性腺瘤性息肉病癌变过程中,肿瘤抑制基因APC出现缺失或突变;遗传性非息肉病性结、直肠癌的发生是由 于HNPCC(hereditary nonpolyposis colorectal cancer)基因异常,表现为基因修复性缺陷而导致复制错误,从而导致细胞异常增殖而形成癌。

某些癌前病变或慢性疾病与大肠癌关系密切。肿瘤性息肉如管状腺瘤、绒毛状腺瘤及管状绒毛状腺瘤,尤绒毛状腺瘤,癌变率可达40%;家族性腺瘤性息肉病发的癌变危险性达100%。慢性溃疡性结肠炎、肠血吸虫病及Crohn病等可通过粘膜上皮异常增生而发生癌变。
(二)病理变化:
大肠癌好发部位为直肠和乙状结肠,其次为盲肠和升结肠,再其次为降结肠和横结肠。少数病人呈多发性,常与多发性息肉癌变所致。
癌限于粘膜下层,无淋巴结转移称早期大肠癌。侵犯肌层者称进展期大肠癌,肉眼可分四型。
1.隆起型 或称息肉型、蕈伞型,肿瘤向腔内外生性生长,有蒂或无蒂,好发于右半结肠。
2.溃疡型 肿瘤表面形成溃疡,可深达肌层,外形如火山口状,伴坏死,好发于直肠和乙状结肠。
3.浸润型 肿瘤在肠壁各层浸润性生长,伴纤维组织增生,致肠壁增厚、狭窄,好发于直肠和乙状结肠。
4.胶样型 外观及切面均呈半透明胶冻状,好发于右侧结肠和直肠。

组织学可分为腺癌(乳头状或管状)伴不同程度分化、粘液腺癌、印戒细胞癌、未分化癌、腺鳞癌、鳞癌等。以腺癌为最多见,腺鳞癌、鳞癌见于直肠与肛管周围。

(三)扩散和转移
1.局部扩散 癌侵及浆膜后可直接累及相邻组织和器官,如腹膜、腹膜后组织、膀胱、子宫和输尿管等,与癌所在部位相关。
2.淋巴道转移 先转移至肠旁淋巴结,再至肠系膜周围及根部淋巴结,晚期可转移到腹股沟、直肠前凹及锁骨上淋巴结。
3.血道转移 晚期易通过门静脉转移至肝,也可经体循环到肺、脑、骨骼等处。
4.种植性转移 癌组织穿透肠壁后脱落种植,常见部位为膀胱直肠凹和子宫直肠凹。
(四)分期和预后
分期依据大肠癌在肠壁的侵及深度以及有否局部淋巴结及远处脏器转移。预后与分期有关。
大肠癌分期及预后(Dukes改良分期)
| 分期 | 肿瘤范围 | 五年存活率(%) |
| A B1 B2 C1 C2 D | 肿瘤限于粘膜层(早期癌) 肿瘤侵及肌层,未穿透,无淋巴结转移 肿瘤穿透肌层,无淋巴结转移 肿瘤未穿透肌层,有淋巴结转移 肿瘤穿透肌层,有淋巴结转移 有远隔脏器转移 | 100 67 54 43 22 极低 |
(五)临床病理联系
早期多无明症状,随肿瘤增大和并发症而出现排便习惯与粪便形状的变化如便秘和腹泻交替,腹部疼痛,腹部肿块,后期出现贫血、消瘦、腹水及恶病质。各种症状中以便血最多见。右侧结肠癌可出现腹部肿块及贫血和中毒症状;左侧易出现狭窄和梗阻伴腹痛、腹胀、便秘和肠蠕动亢进。
四、类癌及类癌综合征
类癌是一种罕见的、生长缓慢的上皮细胞肿瘤,它的组织结构象癌,具有恶变倾向,但较少发生转移,所以称类癌,类癌可发生于食管到直肠消化管中的任何部位,但以阑尾、直肠和回肠最多见,此外,约10%见于支气管、胸腺、甲状腺、卵巢、宫颈和睾丸。
类癌起源于消化道APUD系统中的肠铬细胞,这种细胞能产生生物活性的胺类,故类癌又称肠胺瘤。恶性类癌可转移至肝脏,是血液中血清素(5-羟色胺)等物质增多,临床表现有皮肤潮红、腹痛、腹泻、支气管痉挛和心瓣膜病变等征象,这一组表现称为类癌综合征。
临床表现
1、 皮肤症状:
为最早出现的症状。皮肤出现阵发性潮红,为时短暂,一次发作一般仅5-10分钟,起始在面、颈、胸部,之后扩展至其他部位,呈深红、青紫、苍白的特征性三色变化。有时一天可发作数次。随着病情发展,潮红历时延长,以至变为持续性。支气管类癌患者脸多紫色,持续时间较长,可伴结膜充血、流泪、眶周水肿、心动过速和血压下降。胃类癌患者往往呈组胺性红潮,皮肤呈片状分布的鲜红色,常因进食乳酪、咸肉、火腿、饮酒及情绪激动而发作,此外,皮肤可呈毛细血管扩张及糙皮病样改变。
2、胃肠道症状:
85%的患者,在皮肤潮红的同时有腹痛、腹泻、肠鸣音亢进等表现,腹泻可从每日一次稀便到每日20-30次水样便不等。
五、原发性肝癌
原发性肝癌(primary carcinoma of liver)是由肝细胞或肝内胆管上皮细胞发生的恶性肿瘤,简称肝癌。发病年龄多在中年以上,男多于女。肝癌发病隐匿,早期无临床症状,发现时多已届入晚期。广泛应用血中甲胎蛋白(AFP)测定和影像学检查可提高早期肝癌的检出率,因肝癌患者甲胎蛋白阳性率占70%~98%。
(一)病因及发病机制
以下因素与肝癌发生有关。
1.病毒性肝炎 现知乙型肝炎与肝癌有密切关系,其次为丙型肝炎。
2.肝硬化 肝硬化与肝癌之间有密切关系。据统计,一般需经7年左右肝硬化可发展为肝癌。其中以坏死后性肝硬化为最多,肝炎后肝硬化次之。

3.真菌及其毒素 黄曲霉菌、青霉菌、杂色曲霉菌等都可引起实验性肝癌。其中以黄曲霉菌(aspergillus flavus)最为重要。用该菌或其毒素(aflatoxin,黄曲霉素),或被其污染的食物均可诱发动物肝癌。在肝癌高发区,食物被黄曲霉菌污染的情况往往也较严重。
4.亚硝胺类化合物 从肝癌高发区南非居民的食物中已分离出二甲基亚硝胺。此类化合物也可引起其它处肿瘤如食管癌。
更详细的原发性肝癌病因
(二)病理变化
肉眼类型 早期肝癌也称小肝癌,是指单个癌结节直径在3cm以下或结节数目不超过2个,其直径的总和在3cm以下,患者常无临床症状,而血清AFP阳性的原发性肝癌。瘤结节呈球形或分叶状,灰白色质较软,切面无出血坏死,与周围组织界限清楚。中晚期肝癌,肝体积明显增大可达2000g以上。癌组织可局限于肝的一叶(多为右叶),也可弥散于全肝并大多合并肝硬化。
肉眼可分三型。
1.巨块型 肿瘤为一实体巨块,圆形,直径常大于15cm,多位于肝右叶内。质地较软,中心部常有出血坏死。瘤体周边常有散在的卫星状瘤结节。不合并或合并轻度的肝硬化。

2.多结节型 最多见。瘤结节多个散在,圆形或椭圆形,大小不等,直径由数毫米至数厘米,有的相互融合形成较大的结节。被膜下的瘤结节向表面隆起导致肝表面凹凸不平。常伴有明显的肝硬化,肝内癌栓也颇常见。

3.弥漫型 癌组织在肝内弥漫分布,无明显的结节形成。常发生在肝硬化基础上,此型少见。

按组织发生可将肝癌分为三大类。
1.肝细胞癌 最多见,是由肝细胞发生的肝癌。其分化较好者癌细胞类似肝细胞。分化差者癌细胞异型性明显,常有巨核及多核瘤细胞。有的癌细胞排列成条索状(索状型);亦可呈腺管样(假腺管型)。有时癌组织中有大量纤维组织分割(硬化型)。

(假腺管型)

2.胆管上皮癌 较为少见,是由肝内胆管上皮发生的癌。其组织结构多为腺癌或单纯癌。一般不合并肝硬化。有时继发于华支睾吸虫病。

3.混合性肝癌 具有肝细胞癌及胆管上皮癌两种结构,最少见。
(三)蔓延和转移
肝癌首先在肝内蔓延和转移。癌细胞常沿门静脉播散,在肝内形成转移癌结节,还可逆行蔓延至肝外门静脉主干,形成较大的癌栓,有时可阻塞管腔引起门静脉高压。肝外转移常通过淋巴道转移至肝门淋巴结、上腹部淋巴结和腹膜后淋巴结。晚期可通过肝静脉转移到肺、肾上腺、脑及骨等处。有时肝癌细胞可直接种植到腹膜和卵巢表面,形成种植性转移。
(四)临床病理联系
临床上多有肝硬化病史,进行性消瘦,肝区疼痛、肝迅速增大,黄疸及腹水等表现。有时由于肝表面癌结节自发性破裂或侵破大血管而引起腹腔内大出血 。由于肿瘤压迫肝内外胆管及肝组织广泛破坏而出现黄疸。
六、胰腺癌






























